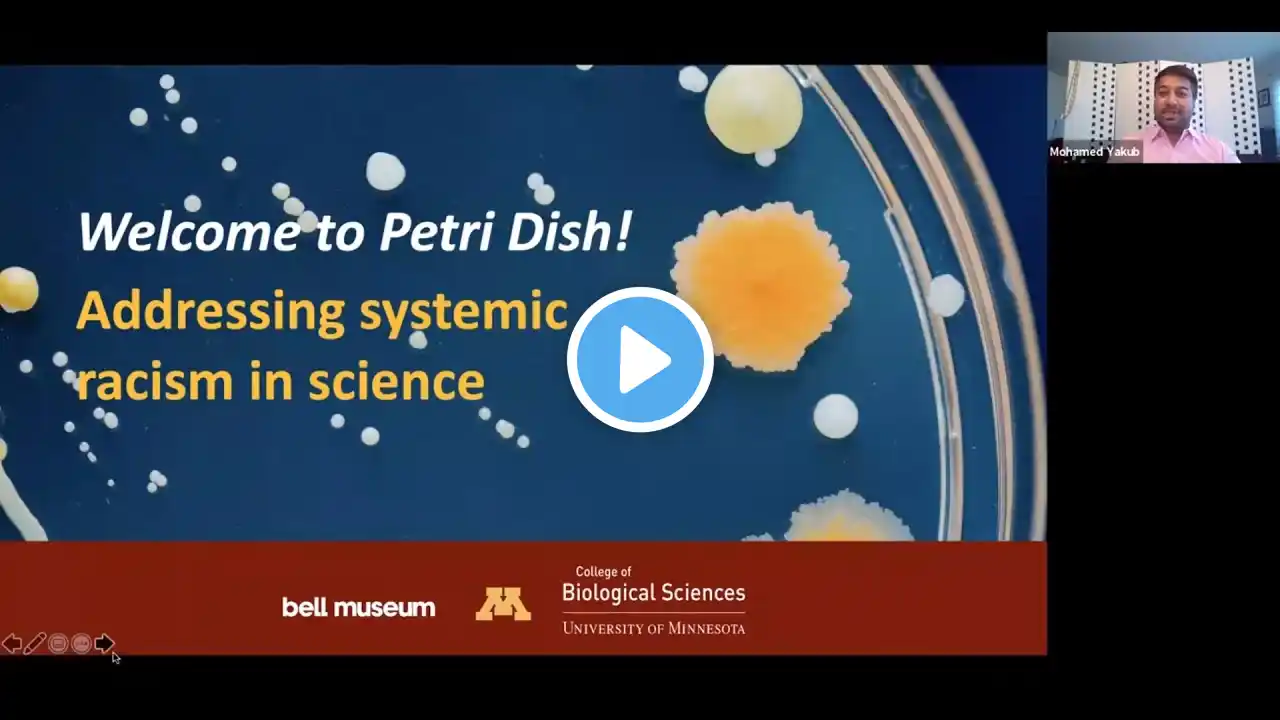
ภาพตัวอย่างวิดีโอ

Research Unplugged: The mutation that became white skin
In this video clip, Dr. Keith Cheng describes the work of another Penn State researcher, Nina Jablonski, suggesting a correlation between skin color and the strength of sunlight across the globe. The evolution of differing skin colors arose as our bodies' adaptation to varied climates and levels of UV exposure, explains Cheng, Professor and Chief of the Division of Experimental Pathology at Penn State Hershey College of Medicine and Co-Director of Penn State IBIOS Bioinformatics and Genomics graduate program. This brief clip was excerpted from Cheng's Spring 2012 Research Unplugged talk titled, "More than Skin Deep: Solving the Genetic Mysteries of Skin Color."